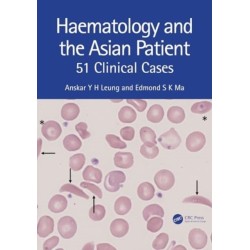
Haematology and the Asian Patient: 51 Clinical Cases

Ingen varer
Der er 15+ underkategorier
Hæmatologi
Visning: Type : Alle | Sprog : Alle | Format : Alle
-
Bemærk: Kan ikke leveres før jul.
Cases in Haematology: for the MLA and PLAB (Bog, Paperback / softback, Engelsk)This book utilises single answer-style questions in the MasterPass series of revision aids, covering the haematology presentations and conditions listed in the... Læs mere
Levering: 6 - 9 hverdage -
Bemærk: Kan ikke leveres før jul.
Cases in Haematology: for the MLA and PLAB (Bog, Hardback, Engelsk)This book utilises single answer-style questions in the MasterPass series of revision aids, covering the haematology presentations and conditions listed in the... Læs mere
Levering: Skaffevare (forvent 14 - 30 hverdage) -
Bemærk: Kan ikke leveres før jul.
Transfusion Medicine and Hemostasis: Clinical and Laboratory Aspects (Bog, Paperback / softback, Engelsk)Levering: 6 - 9 hverdage -
Bemærk: Kan ikke leveres før jul.
Haematology and the Asian Patient: 51 Clinical Cases (Bog, Paperback / softback, Engelsk)It aims to highlight the pathophysiology, clinical presentations and basic principles in the investigations and managements of haematological diseases... Læs mere
Levering: 6 - 9 hverdage -
Bemærk: Kan ikke leveres før jul.
Haematology and the Asian Patient: 51 Clinical Cases (Bog, Hardback, Engelsk)It aims to highlight the pathophysiology, clinical presentations and basic principles in the investigations and managements of haematological diseases... Læs mere
Levering: Skaffevare (forvent 14 - 30 hverdage) -
Bemærk: Kan ikke leveres før jul.
Manual for Night-Time Emergencies for Pediatric Hematology-Oncology Fellows: Should We Chat? (Bog, Paperback / softback, Engelsk)It offers succinct guidelines and algorithms to address the emergencies most likely to come up overnight. For those tempted to turn to AI for quick solutions, there are some salutary lessons from responses AI has given when asked about such emergencies.
Levering: 6 - 9 hverdage -
Bemærk: Kan ikke leveres før jul.
Manual for Night-Time Emergencies for Pediatric Hematology-Oncology Fellows: Should We Chat? (Bog, Hardback, Engelsk)It offers succinct guidelines and algorithms to address the emergencies most likely to come up overnight. For those tempted to turn to AI for quick solutions, there are some salutary lessons from responses AI has given when asked about such emergencies.
Levering: Skaffevare (forvent 14 - 30 hverdage) -
Bemærk: Kan ikke leveres før jul.
Guide to Paediatric Haematology Morphology (Bog, Paperback / softback, Engelsk)This illustrated guide to identifying or confirming blood disorders in paediatric patients presents examples of the abnormal morphology involved. Clinicians in both Haematology and Paediatrics will find this an invaluable resource.
Levering: Skaffevare (forvent 14 - 30 hverdage) -
Bemærk: Kan ikke leveres før jul.
Guide to Paediatric Haematology Morphology (Bog, Hardback, Engelsk)This illustrated guide to identifying or confirming blood disorders in paediatric patients presents examples of the abnormal morphology involved. Clinicians in both Haematology and Paediatrics will find this an invaluable resource.
Levering: Skaffevare (forvent 14 - 30 hverdage) -
Bemærk: Kan ikke leveres før jul.
Oxford Assess and Progress: Clinical Medicine (Bog, Paperback / softback, Engelsk)Containing over 600 Single Best Answer questions, the fourth edition of Oxford Assess and Progress: Clinical Medicine is an essential revision guide.
Levering: 6 - 9 hverdage -
Bemærk: Kan ikke leveres før jul.
Rodak's Hematology: Clinical Principles and Applications (Bog, Paperback / softback, Engelsk)Levering: 6 - 9 hverdage -
Bemærk: Kan ikke leveres før jul.